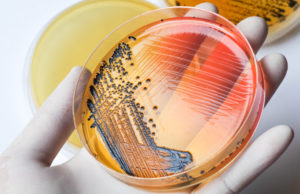
Investigan brote de salmonella en 6 provincias canadienses

Angely Granados
Ordenan detención de Pedro Pablo Kuczynski por lavado de activos vinculado...
La justicia peruana ordenó el arresto del ex presidente Pedro Pablo Kuczynski, a raíz de
una investigación que se le sigue por el presunto delito...
Más de 10 mil canadienses perdieron la vida a causa de...
Más de 10,300
canadienses murieron como resultado de una sobredosis aparente relacionada
con opioides entre enero de 2016 y septiembre de 2018, según informa la Agencia
de...
Conductor de Uber dejó a un cliente en el aeropuerto y...
Un conductor de Uber en California fue arrestado por robar
la casa de un cliente a quien había dejado antes en el aeropuerto. Según el
Departamento...
Canadá se derrite más rápido que el resto del planeta
Los glaciares de la Tierra se están derritiendo mucho más
rápido de lo que los científicos pensaban. Un
nuevo estudio muestra que están perdiendo 369 mil...
Canadá perderá 12,500 empleos de petróleo y gas en 2019
Un nuevo informe señala que se espera que el empleo directo
en el sector de petróleo y gas de Canadá caiga en más de 12,000...
Tres personas han muerto en menos de 8 días en el...
Otro turista murió en el famoso Parque Nacional del Gran
Cañón en el transcurso de una semana. El suceso ocurrió cuando un hombre se
deslizó sobre...
Investigan brote de salmonella en 6 provincias canadienses
Los funcionarios de salud están investigando un brote de
salmonella en seis provincias que ha enfermado a 63 personas, incluidas 18 que
han sido hospitalizadas. La...
Ontario podría implementar exámenes anuales de matemáticas obligatorios para todos los...
El gobierno de Ontario está considerando implementar
exámenes de matemáticas anuales obligatorios para todos los maestros en la
provincia. Fuentes gubernamentales han revelado a The Canadian...
Cada día más de 40 albertanos se declaran en bancarrota
De acuerdo con los últimos datos del Superintendente de
Bancarrota de Canadá, más y más personas de Alberta no pueden pagar sus deudas.
Hubo 14.696 insolvencias...
Canadiense descubre una fortuna en una antigua piedra familiar
Abraham Reyes, un hombre de 38 años, se volvió millonario
repentinamente gracias a una reliquia familiar. Sus parientes, habían conservado lo que parecía ser un
diente...